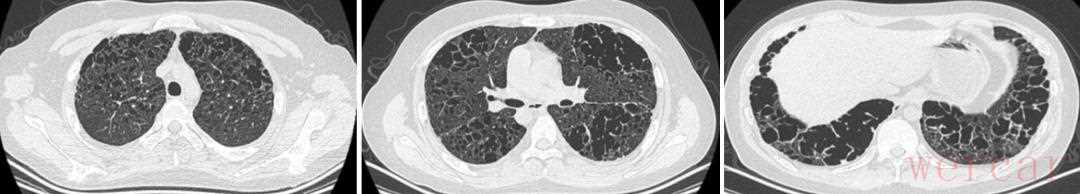

患者饮冷水诱发胸痛气短,追溯四年奇症揭秘病因
这是一个典型的医学诊断推理案例。让我们来分析一下:
"患者情况:"
"症状:" 饮冷水后突然出现右侧胸痛和气短。
"关键信息:" 追问出4年前有“奇怪现象”。
"推理过程:"
1. "初步分析症状:"
"饮冷水后诱发:" 这是非常关键的信息。冷刺激可能诱发或加重某些特定的症状。
"右侧胸痛:" 胸痛的定位(右侧)很重要。
"气短 (Dyspnea):" 呼吸困难,提示呼吸系统或心脏功能可能受影响。
2. "结合关键信息“4年前的奇怪现象”:" 这是解开谜团的核心。我们需要设想4年前患者可能经历过什么“奇怪现象”,这个现象必须与现在的症状有联系,并且潜伏了4年。
3. "可能的疾病联想:"
考虑到冷刺激和胸痛,"胸膜病变"是首要怀疑对象,特别是"自发性气胸 (Spontaneous Pneumothorax)"。气胸是指肺部萎陷,导致胸膜腔内积气。
"首次发生气胸的“奇怪现象”可能是什么?"
"症状模糊或不典型:" 患者当时可能只感到短暂的胸痛、胸闷,或者根本没注意到,
相关内容:

引言面对临床中的一些错综复杂的病例,医师们的诊断思路历程如何?他们怎样总结得失?……围绕肺炎型肺癌、LAM、COP、EGPA、复发性多软骨炎、MDA5阳性皮肌炎、IgG4病、PHLC、重症肺炎以及发热待查等多个角度,我们了西安交通大学第二附属医院呼吸与危重症医学科主任杨拴盈教授的专家团队,经过一个多月的精心策划和准备,今日起隆重推出「疑案探密」系列,与同道分享。
患者一次饮冷水后突然出现右侧胸痛、气短……没有病理确诊证据,但已排除其它可能的双肺多发囊性疾病,他到底是什么病因?
患者当时正读大四,是个刚满21岁的男孩。他因「气短1月余」,于2017年2月在我院呼吸与危重症医学科就诊。
患者在就诊1月余前,一次饮冷水后突然出现右侧胸痛、气短,在常州市某医院急诊行胸部CT检查,提示右侧液气胸,行右侧胸腔闭式引流术后,气短及胸痛好转。肺组织复张后行胸部高分辨CT,发现「双肺弥漫性间质性改变、双肺多发肺大泡」。先后在常州、陕西及北京多家医院就诊,均未明确诊断,患者活动时仍有轻度气短。为求进一步诊治来到我院,门诊以「双肺多发囊状影性质待查」收住。自发病以来,患者神志清楚,精神和饮食状况尚可,大小便也正常。我们详细了解了患者的病史,患者自述既往身体健康,没有家族遗传病史,也并未有疫区疫水接触史,无吸烟喝酒等不良嗜好,但其父亲长期吸烟,在大学里也有寝室室友吸烟。
对患者进行查体的情况:T37.1℃,听诊双肺呼吸音清,未闻及干湿啰音。心腹查体未见明显异常。入院前辅助检查情况如下:
(1)胸部CT(2016年12月25日,常州市某医院):右侧液气胸。

2016年12月25日 胸部CT
(2)胸部CT(2016年12月30日,常州市某医院):双肺弥漫性间质改变、双肺多发肺大泡。

2016.12.30 胸部CT
(3)胸部CT(2017年1月11日,常州市某医院):双肺多发肺大泡。

2017年1月11日 胸部CT
对患者入院的初步诊断
双肺多发囊状影性质待查:1、肺郎格罕细胞组织细胞增生症,2、LAM,3、Birt-Hogg Dube综合征,4、脂质肉芽肿病。
入院后,给予吸氧及「头孢曲松」等治疗。入院后又复查胸部CT:1.两肺弥漫囊性病变(肺外带及下野较为著),部分呈蜂窝样改变,并多发小结节影;2.双侧胸膜增厚、粘连。
2017年2月6日 胸部CT
一再追问病史后发现患者4年前曾出现多饮多尿,最多每天饮水达4500ml……他的多饮多尿、干咳与头皮瘙痒等症状到底与病因有关系吗?
初步诊断不一定就是患者的真实病因。患者入院后,我们继续积极完善他的相关检查,排查其它疾病。在做肺功能后发现,患者的肺功能提示混合性通气功能障碍,(FEV1/FVC 69.04%,FEV1%pred 35.3%),弥散功能减低。做血气分析示(未吸氧):PH 7.453,PCO2 35.6mmHg,PO2 67.4mmHg,SaO2 93.9%。腹部彩超提示肝、胆、胰、脾及双肾未见异常。心脏彩超提示三尖瓣轻度反流。结核感染特异性T淋巴细胞阴性,结核杆菌抗体阴性。EB病毒DNA及巨细胞病毒定量正常。自身免疫全套、风湿系列及抗中性粒细胞抗体均正常。肿瘤标志物:癌胚抗原正常,神经元特异性烯醇化酶37.36 ng/ml轻度↑、非小细胞肺癌相关抗原3.56 ng/ml轻度↑,糖类抗原125 75.47ng/ml轻度↑。甲功系列:TSH 6.06 uIU/ml轻度↑。血清皮质醇(CORT)667.10 nmol/L轻度↑。性激素六项:雌二醇(E2)<5.00 pg/ml↓、促卵泡生成素(FSH)0.70 mIU/ml↓、催乳素(PRL)18.21 ng/ml↑、睾酮(TESTO)21.36 ng/dl↓、孕酮(PROG)0.243 ng/ml、促黄体生成素(LH)2.39 mIU/ml。垂体增强MRI提示垂体柄增粗并强化不均。在X线下透视颅骨和中轴骨未见异常。

2017年2月13 垂体增强MR
拿到这些详细的检查报告后,我们又仔细地追问患者病史,最终经患者回忆,自己在就诊时的4年前(2013年)曾经出现过多饮多尿,最多的时候每天饮水达4500ml,但当时可以自行控制饮水到正常量,也就没有太注意。患者当时正在备战高考,没有就这个症状进行诊治,高考结束后,也曾到当地和北京就诊,当时医生考虑他的症状和青春期发育有关,建议观察。
可是,患者在就诊时的2年前(2015年2月),仍有多饮多尿的现象,除此之外还有轻度的干咳。做头颅MRI提示垂体漏斗部增粗,查尿比重为1.000,行性激素检查提示促卵泡生成素、睾酮低。胸片报告未见明显异常。仍建议观察。
就在患者在就诊时的8个月前(2016年10月),干咳症状开始加重。患者到常州市某院行胸部CT检查,显示两肺呈多发微小结节影,并可见多发类圆形无肺纹理透亮区。医院给予了对症止咳治疗,效果欠佳。患者同时出现头皮瘙痒,诊断为脂溢性皮炎,外用药物治疗,效果良好,皮炎完全缓解。

2016年10月 胸部CT
综合分析一下患者的病情发展,4年前,出现多饮多尿;2年前,头颅MRI提示垂体漏斗部增粗,此次入院垂体增强MRI提示垂体柄增粗并强化不均;查尿比重为1.000,行性激素检查提示性腺功能减退,甲功示亚临床甲减;8月前,出现皮肤瘙痒,诊断为脂溢性皮炎,经治疗后好转;同时还出现干咳,胸部HRCT显示可见多发微小结节影,随后胸部CT囊状阴影逐渐增多,结节减少,蜂窝肺逐渐出现。综合所有这些症状,结合患者青年男性,有吸二手烟史,我们总结这个患者是以「多饮多尿、垂体柄增粗并强化不均、脂溢性皮炎、双肺多发结节及囊性阴影」等多系统损害为特点,于是经过入院检查后排除了炎症、肿瘤、结核、自身免疫性疾病以及其它双肺囊性病变,临床诊断为郎格罕细胞组织细胞增生症。
郎格罕细胞组织细胞增生症(Langerhans cell histiocytosis,LCH),是—种病因和发病机制均不明的罕见疾病,以大量郎格罕组织细胞的异常增殖、浸润和肉芽肿形成,导致器官功能障碍为特征。曾称为组织细胞增生症X(Histiocytosis X),包括嗜酸性肉芽肿(EGB)、勒-雪病(Letterer-Siwe disease, LS)和韩-薛-柯病(Hand-Schuller-Christian disease, HSC)3种严重程度不同的临床综合征。LCH的基本病理改变是分化较好的组织细胞浸润,全身均可受累,尤以含组织细胞丰富的肺、肝、脾、骨髓、淋巴结、垂体、皮肤为著,呈局限或广泛的反应性或肿瘤性增生为特点。电镜在病变细胞内发现Birbeck颗粒和/或CD1a抗原阳性可确诊此病。
LCH可表现为单系统损害,如骨骼、皮肤、肺、下丘脑、垂体/中枢神经系统、甲状腺或胸腺等脏器受累。也可表现为≥2个脏器/系统受累。中枢神经系统因下丘脑—垂体区域浸润表现为尿崩症、生长激素缺乏、继发性甲状腺功能减低、性腺发育不良等。胸部正位片表现为中上肺野分布的网状结节影,常不累及肋膈角,高分辨CT典型的进展是从边界不清的微小结节(直径1-5mm)到囊状影和结节并存,在疾病的晚期有结节消退和囊状影增大的表现,囊状影形状各异。典型的患者可通过高分辨CT做出临床诊断。确定诊断还需结合临床表现、实验室检查和病理学结果。
患者肺部病变进展较快,预后不佳,与时间的拖延难脱干系……这种病主要应该与哪几种病进行鉴别诊断?要最终确诊还应该进行哪些检查?
我们要明确诊断,主要应该与哪些病进行鉴别诊断?又该如何鉴别诊断?
1、肺淋巴管肌瘤病(lymphangiomyomatosis,LAM):几乎只发生于育龄期妇女,胸部CT为双肺均匀分布的2-20mm的薄壁囊状影,囊壁光滑,晚期可完全替代正常肺组织;常出现反复气胸,可伴有乳糜胸、肾血管平滑肌脂肪瘤、淋巴管瘤等疾病。
2、淋巴细胞间质性肺炎(lymphocytic interstitial pneumonia,LIP):是一种良性的淋巴细胞增殖性疾病,常合并系统性疾病(艾滋病、EB病毒感染等)或者结缔组织病(干燥综合征、类风湿关节炎、系统性红斑狼疮等),女性好发,胸部CT可表现为薄壁囊泡,多为细支气管、血管旁及胸膜下分布。与其它囊性改变的肺部疾病相比,该病的囊泡较大(最大直径可达 3 cm),并且数量较少。
3、脂质肉芽肿病:又称Erdheim-Chester病,非郎格罕细胞组织细胞增生症,均有长骨骨质硬化,胸部CT表现为小叶间隔增厚、小叶中心性结节、磨玻璃影,也可出现肺部囊性病变,病理CD68阳性,但CD1α阴性。
4、Birt-Hogg Dube综合征:表现为常染色体显性遗传的三联征:纤维毛囊瘤、肾细胞癌及肺囊肿。胸部CT主要为多发的边界清楚的薄壁囊泡,数量极少。
上述四种疾病均可表现为肺部囊性病变,但该例患者不是育龄期妇女,胸部CT并非均匀分布的薄壁囊状阴影,故不考虑肺淋巴管肌瘤病。未合并系统性疾病和结缔组织疾病,胸部CT也不符合囊泡大且少的特点,故淋巴细胞间质性肺炎可能性小。无长骨骨质硬化,不考虑脂质肉芽肿。无纤维毛囊瘤和肾细胞癌,不考虑Birt-Hogg Dube综合征。患者脂溢性皮炎及中枢神经系统的表现,胸部CT早期可见较多小结节,但随病情的进展,囊状影逐渐增多,最终表现为蜂窝肺,这些均符合郎格罕细胞组织细胞增生症的特点,但它分布以中下肺为主并非LCH的常见表现,尽管如此,我们综合分析郎格罕细胞组织细胞增生症可能性最大。因此,为了进一步确诊患者的疾病,我们建议行肺穿或外科胸腔镜下肺活检进一步明确诊断。
目前,LCH还没有特别有效的治疗方案。戒烟是最重要的措施,75%的患者戒烟后6-24月病情稳定或好转。激素对该病可能有一定的疗效,常规剂量为0.5-1.0mg/(kg.d),逐渐减量期为6-12个月。仅在高分辨CT上以小结节表现为主的患者不推荐应用。目前不推荐使用细胞毒性药物。儿童多系统LCH基本治疗方案是使用长春新碱和强的松。治疗需持续1年,因为与治疗6个月相比能降低复发率。然而长春新碱/强的松基本疗法对大多数成人LCH无效,并且在成人LCH治疗的随机双盲试验中,尚未证明化疗有效。伴发气胸患者可行胸膜固定术。部分患者BRAFV600E基因突变阳性,可给予靶向治疗。终末期LCH患者可能发展为肺动脉高压,此时肺移植是一种治疗选择,但可能有20%的患者病情会复发。结合该患者的病情,我们建议:1、避免接触二手烟;2、可给予激素治疗;3、行血BRAFV600E基因检测;4、肺移植。
由于该患者病情进展迅速,双肺组织破坏严重,现有的治疗方法疗效均不确切,家属拒绝了肺穿或肺活检进一步确诊,同意于2017年2月14日开始口服强的松30mgQD,并给予抑酸、补钾及保护胃黏膜治疗。患者于2017年2月17日中午,突然出现胸闷、气短、呼吸困难、大汗淋漓,指脉氧饱和度下降至74%,左肺叩诊呈鼓音,听诊左肺呼吸音消失。考虑左侧气胸,行左侧胸腔置管,先后抽出6300ml气体,指脉氧饱和度升至83%,仍可轻松抽出气体。后行左侧胸腔闭式引流术,指脉氧饱和度升至90%,患者气短好转。

第二日(2月18日)凌晨1点30分,患者饮水呛咳后,再次出现呼吸困难,血氧饱和度下降,复查床头胸部正位片(2月18日)示左肺已复张,但右肺压缩近90%。立即行右侧胸腔闭式引流术。随后,患者出现发热,痰培养出现敏感鲍曼不动杆菌。给予敏感抗生素治疗,体温渐降。但闭式引流不能使肺复张,患者仍诉气短呼吸困难,复查床头胸部正位片(2017年2月23日)示右肺未完全复张,左肺再次被压缩近15%。遂给予床头负压吸引,但效果仍不佳。吸氧5升/分,复查动脉血气示(2017年2月24日)PH 7.365,PCO2 53.4mmHg,PO2 60.6mmHg,SaO2 89.3%,BE 3.3mmol/l。颈部和前胸部触及皮下捻发感,复查床头胸部正位片示双侧气胸,引流管内一直有气泡涌出,可能形成了交通性气胸和/或不断有肺泡破裂,导致无法拔除闭式引流管。多次请胸外科会诊,可否行胸膜修补术或胸膜固定术?但胸外科医师分析患者胸部CT,认为肺组织严重弥漫性破坏,胸腔镜下胸膜修补或固定术难以实施。患者疾病进展迅速,2017年2月28日复查床头胸部正位片示双侧气胸,皮下气肿,可疑纵隔气肿。最终,家属决定转回当地医院治疗。 尽管LCH是一种罕见病,但其在早期也有一些蛛丝马迹,如多饮多尿,CT片上的多发囊状影及小结节、垂体形态的改变、尿比重下降等。如能早期识别,预后可能完全不同。遗憾的是这例患者诊断时已属晚期,肺组织严重破坏,又缺乏有效的治疗方法,加之疾病进展快,预后不佳。
提示我们:临床医师必须要有渊博的知识和扎实的基本功;反复、仔细追问病史,认真全面检查,对任何可疑线索都不能轻易放过;对不同的疾病,选择正确的检查方法非常重要,如肺部有小病灶或间质改变时应选择HRCT;当诊断遇到困难时,要先考虑常见病,再考虑少见或罕见病,不能想当然,要查文献,组织MDT等,观察要有计划和时间节点。只有这样,才可能在早期做出诊断,减少漏诊和误诊,为后续治疗赢得宝贵时间。
专家介绍
杨拴盈一级主任医师,教授,博士生及博士后导师。西安交通大学第二附属医院呼吸与危重症医学科主任。教育部新世纪优秀人才。中华医学会呼吸分会委员;中华医学会呼吸分会肺癌学组委员;中国呼吸医师协会肺癌工作委员会委员;国际肺癌研究会会员;《中华结核和呼吸杂志》、《中华肺部疾病杂志》、《中国肺癌杂志》、《国际呼吸杂志》《现代肿瘤医学》、《中国呼吸与危重症杂志》、《西安交通大学学报(医学版)》常务编委或编委。主持国家自然科学基金4项,发表论文182篇,SCI 53篇,获省科技进步二等奖2项,主编专著1部,参与制定肺癌诊疗相关指南、共识13部。
李维西安交通大学第二附属医院呼吸与危重症医学科副主任医师,临床医学博士,任陕西省抗癌协会肿瘤个体化诊疗专业委员会委员、陕西省抗癌协会化疗专业委员会青年委员会委员、陕西省保健学会过敏性疾病防治专业委员会常委。熟练掌握呼吸内科常见病及多发病的诊治,尤其在肺部阴影、肺部结节的诊断和鉴别诊断及肺癌的治疗方面积累了一定的经验。熟练支气管镜检查、超声支气管镜检查、胸腔镜检查、CT引导下经皮肺穿刺术、支气管热成形术等呼吸科常用诊疗技术。主要研究方向为肺癌的早期诊断及治疗。
张秋红主治医师,博士在读。2003年起就读于西安交通大学临床医学(七年制),2010年毕业后留西安交通大学第二附属医院呼吸内科工作至今。任陕西省抗癌协会肿瘤个体化诊疗专业委员会委员、陕西省老年病学会呼吸学会委员。发表核心期刊论文数篇,主持陕西省重点研发计划社会发展领域项目一项。在带教工作中曾获优秀教师称号。在呼吸内科常见病如慢阻肺、哮喘、支气管扩张、肺炎、肺间质纤维化、胸腔积液等疾病诊治方面经验丰富,尤其擅长肺癌的诊治、疼痛规范化治疗、呼吸危重症患者的救治。熟练掌握胸腔穿刺置管闭式引流术、CT引导下经皮肺穿刺活检、内科胸腔镜、支气管镜等技术。
本文完采写编辑:冬雪凝;今日排版:大奔
1